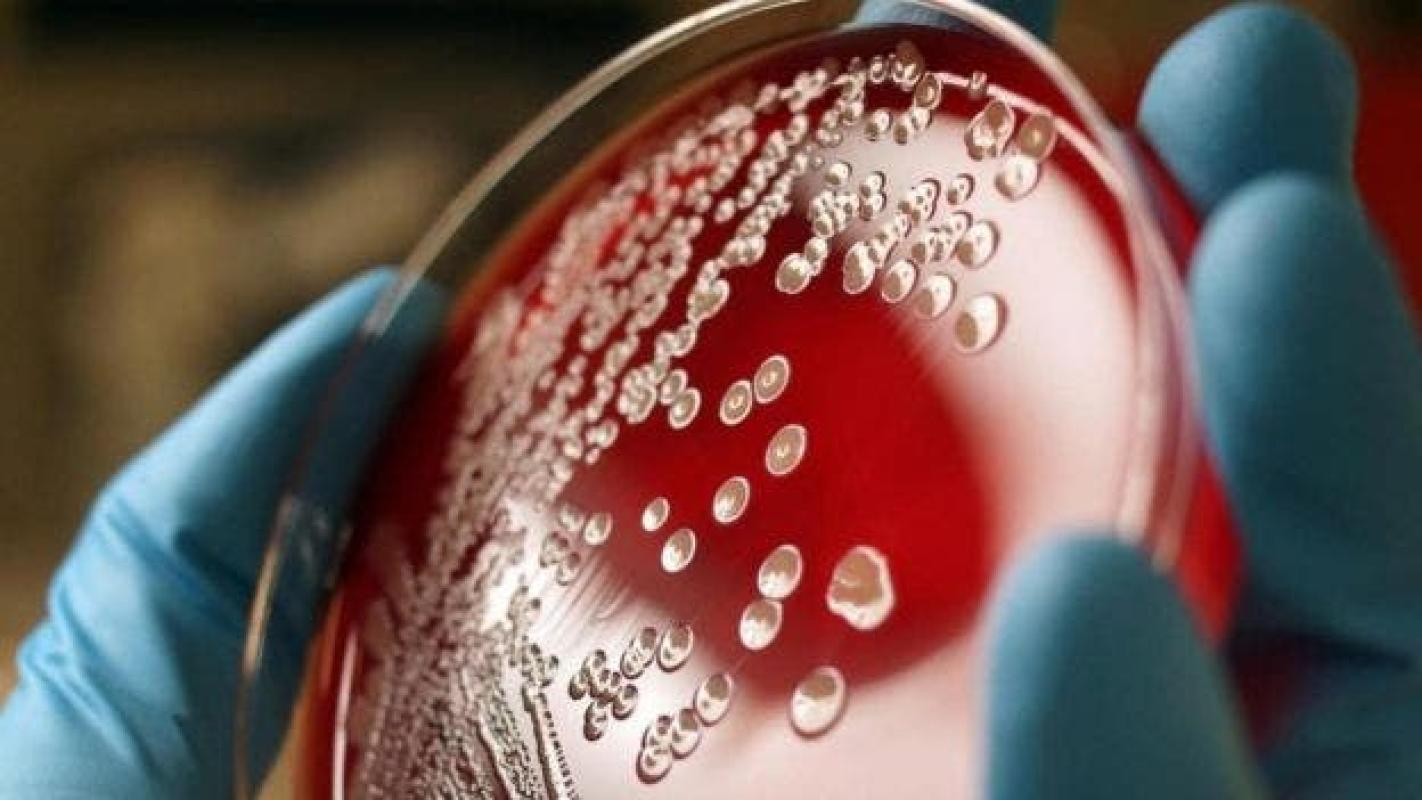

Algunas bacterias de nuestros intestinos tienen al menos 15 millones de años
Algunas bacterias de nuestros intestinos tienen al menos 15 millones de años
Algunas bacterias de nuestros intestinos tienen al menos 15 millones de años
T13 En Vivo
AFP
Ciertas bacterias intestinales se remontan hace al menos 15 millones de años, mucho antes de que nos convirtiéramos en humanos, según una investigación publicada este jueves.
Este descubrimiento sugiere que la evolución juega un papel más grande en la composición de la macrobiótica intestinal de lo que se pensaba, según los investigadores, cuyos trabajos se publicaron en la revista estadounidense Science.
Estas bacterias contribuyen a los primeros estadios del desarrollo de nuestros intestinos, entrenan a nuestro sistema inmunitario a combatir los agentes patógenos e incluso podrían afectar a nuestro humor y comportamiento, precisa.
Cuando los humanos y los grandes primates evolucionaron en especies diferentes a partir de un ancestro común, las bacterias presentes en los intestinos de este último también evolucionaron en cepas diferentes, determinaron los científicos.
Así, la primera diferenciación de las bacterias intestinales se produjo hace aproximadamente 15,6 millones de años, cuando la línea de los gorilas divergió de la del resto de los homínidos.
La segunda surgió hace 5,3 millones de años, en el momento en que la rama humana se separó de la de los chimpancés y los bonobos.
"Sabíamos desde hacía tiempo que los humanos y nuestros primos más cercanos, los grandes monos, tienen estas bacterias en sus intestinos", indica Andrew Moeller, investigador de la Universidad de California en Berkeley y uno de los coautores del estudio.
"La mayor pregunta que queríamos responder era de dónde procedían esas bacterias, si de nuestro entorno o de nuestra evolución, y cuánto tiempo se mantuvieron los linajes", añade.
Para llevar a cabo su investigación, los científicos analizaron muestras fecales de chimpancés, de bonobos y de gorilas que viven en estado salvaje en África, y de personas en Estados Unidos.
Los fósiles y los índices genéticos permitieron establecer que esas cuatro especies de homínidos evolucionaron a partir de un ancestro común que vivía hace más de 10 millones de años.










